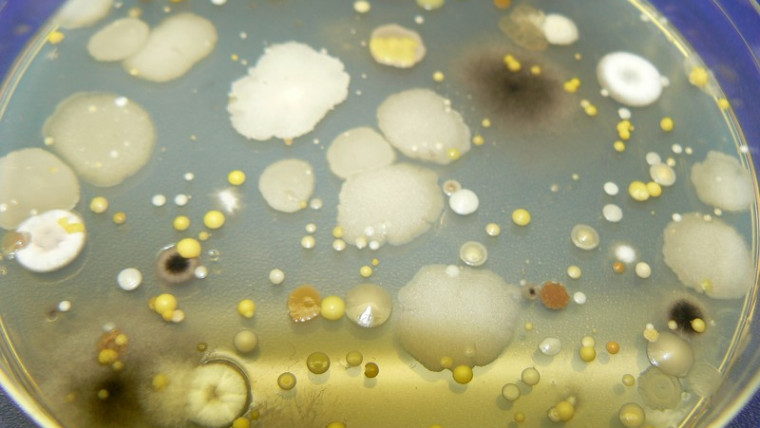

Henry Sicilia dimite como presidente de Asprocan
Sicilia, que fue elegido en abril de 2016 presidente de Asprocan, será sustituido por el vicepresidente de esta asociación, Domingo Martín, según establecen los estatutos de esta organización en el caso de dimisión del presidente. Martín ocupará la presidencia hasta…
Asaja-A pide más fondos jóvenes agricultores tras aprobarse 20 por ciento solicitudes
La Consejería de Agricultura ha publicado los listados provisionales de expedientes aprobados, denegados y suplentes, y según los primeros cálculos, "sólo se podrán incorporar 475 jóvenes en toda Andalucía, el 20 por ciento de todos los solicitantes". De los 2.389…
Unión Uniones valora reducción 14 por ciento robos campo en 2016 pero pide más medidas
En un comunicado, la organización agraria ha reclamado más medios para reducir de forma considerable los delitos en las explotaciones que, no obstante, han bajado desde los 24.078 contabilizados en 2013 (21.146 en 2014), según datos del Ministerio del Interior…
Torrelavega adjudica 90 huertos urbanos con nueva norma
En rueda de prensa, el concejal de Medio Ambiente, José Luis Urraca Casal, ha explicado que la adjudicación se llevará a cabo mediante concurrencia competitiva entre los interesados, a los que se pedirá que justifiquen su situación de desempleo, jubilación…
Soltir y Mercagrisa lideran la inversión para la confección del pimiento
Las empresas de Murcia Soltir y Mercagrisa lideran la inversión en mejorar la confección y manipulación del pimiento de la campaña de primavera. Ambas empresas han invertido sobre los 200.000 euros en un calibrado para incrementar la confección del California…
Más de 150 agentes en operativo contra robos en campo alicantino
Este plan de seguridad tiene como objetivos prevenir las amenazas detectadas para la seguridad en las diferentes zonas de la comarca, fomentar la confianza de los residentes y agricultores en las Fuerzas y Cuerpos de Seguridad del Estado y en…
Piden que se pueda exportar papas tras el tratamiento contra la polilla
Una nota de la Consejería de Agricultura indica que el Ministerio de Agricultura ha reconocido la efectividad del tratamiento que han desarrollado ambas instituciones en colaboración con la Universidad de La Laguna. El protocolo para la eliminación de la polilla…
Madrid acogerá el II Congreso de investigación agraria para el desarrollo
El Congreso está organizado por el Instituto Nacional de Investigación y Tecnología Agraria y Alimentaria (INIA), la Consejería de Medio Ambiente, Administración Local y Ordenación del territorio de la Comunidad de Madrid, la Agencia Española de Cooperación Internacional para el…